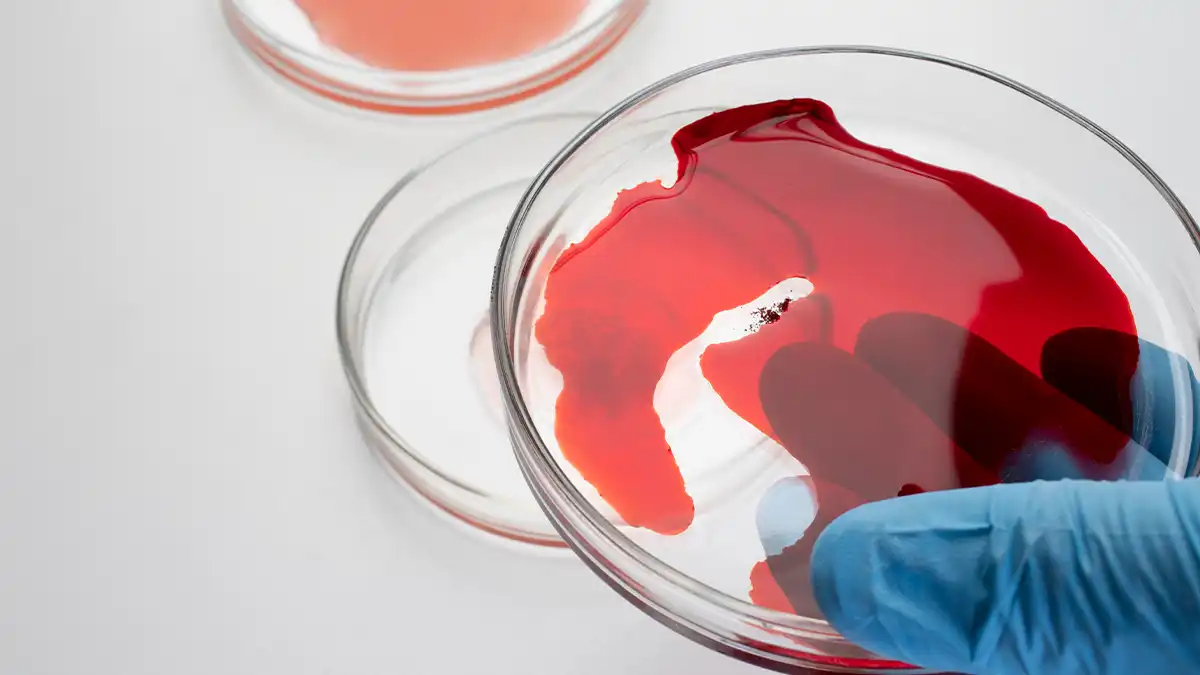
روش های پیشگیری از لخته خون در پا

لخته شدن خون چیست و چه خطراتی به همراه دارد؟
لخته شدن خون یک فرآیند طبیعی است که به جلوگیری از خونریزی در بدن کمک میکند,اما آیا لخته خون باعث مرگ می شود ؟
وقتی یک عروق خونی آسیب میبیند، پلاکت ها و پروتئین های خاص به هم پیوسته و لخته ای تشکیل میدهند. اما گاهی اوقات، این لخته ها در جاهای نادرست ایجاد میشوند و میتوانند مشکلات جدی به وجود آورند. بهعنوان مثال، لخته شدن خون در عروق پاها میتواند به بیماری ای به نام “ترومبوز ورید عمقی” (DVT) منجر شود.
این وضعیت خطرناک است زیرا لخته خون ممکن است به ریهها منتقل شده و باعث “آمبولی ریه” شود. این نوع از لخته خونی میتواند علائمی مانند ورم، درد و تغییر رنگ در ناحیه آسیبدیده ایجاد کند. در نهایت، پیشگیری از لخته شدن خون در پاها از اهمیت بالایی برخوردار است و میتوان با تغییرات سبک زندگی و مصرف داروهای مناسب و استفاده از دستگاه های پنوماتیک دی وی تی ، خطرات آن را کاهش داد.
پمپ DVT
پمپ DVT آنهوما،راه حلی مطمئن برای پیشگیری از لخته خون در پا
❤️ +421 نفر این کالا را پسندیدهاند


لخته شدن خون در پا چه خطراتی دارد ؟ آیا لخته خون باعث مرگ می شود ؟
لخته شدن خون در پا یا ترومبوز ورید عمقی (DVT) یکی از اختلالات شایع اما خطرناک در سیستم گردش خون است. این وضعیت میتواند عواقب جدی و گاهی تهدیدکننده برای زندگی به همراه داشته باشد، بهویژه اگر به موقع تشخیص داده نشود یا درمان مناسب صورت نگیرد اما آیا لخته خون در پا باعث مرگ می شود ؟در ادامه مقاله با ما همراه باشید. مهمترین خطرات لخته شدن خون در پا عبارتند از:
- آمبولی ریه (Pulmonary Embolism)
- خطرناکترین پیامد DVT، جدا شدن بخشی از لخته و حرکت آن به سمت ریههاست که ممکن است باعث انسداد شریانهای ریوی و در برخی موارد، مرگ ناگهانی شود.
- سندروم پس از ترومبوز (Post-thrombotic Syndrome)
- این سندروم میتواند منجر به درد مزمن، تورم، تغییر رنگ پوست و حتی زخمهای مقاوم در پا شود.
- تورم و درد مزمن در پاها
- لخته شدن خون ممکن است جریان طبیعی خون را مختل کرده و باعث احساس سنگینی، درد و ناراحتی مداوم در پا شود.
- افزایش خطر لخته مجدد
- بیمارانی که یکبار دچار لخته شدن خون در پا شدهاند، بیشتر در معرض خطر لختههای بعدی هستند، بهخصوص اگر علت زمینهای درمان نشود.
- نیاز به درمان طولانیمدت
- بسته به شرایط بیمار، ممکن است مدت زمان درمان لخته خون در پا طولانی باشد و شامل داروهای ضدانعقاد، مراقبت در منزل، و تغییر سبک زندگی گردد.
بیشتر بخوانید: چاقی و دی وی تی

علائم لخته شدن خون در پاها : راه های تشخیص لخته شدن خون
تشخیص زودهنگام لخته شدن خون بسیار مهم است تا از عوارض جدی جلوگیری شود. برخی از علائم اولیه لخته های خونی شامل درد، تورم و قرمزی در ناحیه آسیبدیده است. بهویژه در نواحی مانند پاها، احساس سنگینی و گرمی میتواند نشانه لخته شدن خون باشد. همچنین، در صورت بروز مشکل در تنفس یا درد قفسه سینه، این میتواند به وجود لخته های خونی در ریهها اشاره کند که نیاز به توجه فوری پزشکی دارد.
دیگر علائمی که باید به آنها توجه کرد، تغییر رنگ پوست و وجود رگهای متورم در ناحیه آسیبدیده است. اگر به این علائم توجه نشود، ممکن است عوارض جدی مانند آمبولی ریه یا سکته قلبی رخ دهد. در نتیجه، آگاهی از علائم لخته شدن خون و مراجعه به پزشک در صورت بروز هرگونه مشکل، از اهمیت بالایی برخوردار است.
در برخی شرایط پزشک معالج به شما توصیه می کند تا از جوراب های پنوماتیک دی وی تی استفاده کنید تا از ایجاد بخته خون در پاهای خود جلوگیری کنید؛جوراب های پنوماتیک دی وی تی آنهوما را می توانید از 2 ساعت تا 24 ساعت بسته به تجویز پزشک خود استفاده کنید.
جوراب ضد آمبولی دائم آنهوما
با جوراب های دائم آنتی آمبولی آنهوما دیگر نگران لخته شدن خون در پا نباشید
❤️ +541 نفر این کالا را پسندیدهاند

روشهای طبیعی برای پیشگیری از لخته خون در پا
پیشگیری از لخته شدن خون یکی از نکات کلیدی در حفظ سلامت است. چندین روش طبیعی وجود دارد که میتواند به کاهش خطر تشکیل لخته کمک کند. یکی از این روشها، افزایش فعالیت بدنی است. ورزش منظم میتواند گردش خون را بهبود بخشد و از ایجاد لخته های خونی جلوگیری کند. همچنین، مصرف غذاهای غنی از امگا-3 مانند ماهی، دانههای کتان و گردو به رقیق شدن خون کمک میکند.
همچنین، مایعات کافی و آبمیوههای طبیعی میتوانند نقش مهمی در حفظ رطوبت بدن و کاهش خطر لخته شدن خون داشته باشند. دیگر نکته مهم، کاهش استرس از طریق مدیتیشن یا یوگا است که میتواند به بهبود سلامت کلی بدن کمک کند. در نهایت، ترک سیگار و مصرف مشروبات الکلی بهمقدار کم نیز به پیشگیری از لخته شدن خون کمک خواهد کرد.

لخته شدن خون در پا
لخته شدن خون در پا که معمولاً به نام ترومبوز ورید عمقی (DVT) شناخته میشود، یکی از عارضههای جدی گردش خون است که در صورت بیتوجهی میتواند خطرناک باشد. این وضعیت معمولاً در اثر تجمع سلولهای خونی و اختلال در جریان خون در وریدهای عمقی پا ایجاد میشود. لخته شدن خون در پا ممکن است منجر به درد، ورم و حتی آمبولی ریه شود. تشخیص و درمان بهموقع این مشکل برای پیشگیری از عوارض جدی حیاتی است.
علائم لخته شدن خون در پا
علائم لخته شدن خون در پا شامل ورم ناگهانی، درد مداوم یا تیر کشنده در ساق یا ران، قرمزی یا تغییر رنگ پوست و احساس گرما در ناحیه درگیر است. در برخی موارد، این علائم به اشتباه با گرفتگی عضلات یا آسیبهای دیگر اشتباه گرفته میشود، به همین دلیل توجه به نشانههای ظریف اهمیت زیادی دارد.
پیشگیری از لخته شدن در پا
برای پیشگیری از لخته شدن خون در پا، توصیه میشود تحرک کافی داشته باشید، مخصوصاً در سفرهای طولانی یا پس از جراحی. نوشیدن آب کافی، پوشیدن جورابهای فشاری، ترک سیگار و پرهیز از نشستن یا ایستادن طولانیمدت نیز از راهکارهای مؤثر هستند. افرادی که سابقه خانوادگی یا عوامل خطر دارند باید تحت نظر پزشک باشند.

آیا لخته خون در پا باعث مرگ می شود؟
آیا لخته خون در پا باعث مرگ می شود؟ این پرسش ذهن بسیاری از افرادی را درگیر میکند که بهدلایل مختلفی مانند بیتحرکی طولانی، جراحیهای ارتوپدی یا بارداری، در معرض خطر تشکیل لختههای خونی قرار دارند. لخته خون در پا که اغلب بهعنوان ترومبوز ورید عمقی (DVT) شناخته میشود، اگر بهموقع تشخیص داده نشود، میتواند عوارض جدی و حتی مرگبار ایجاد کند.
به همین دلیل، پاسخ به این سؤال که “آیا لخته خون در پا باعث مرگ می شود” باید با دقت و با آگاهی کامل از مسیرهای خطر آن بررسی شود. مهمترین خطری که در اثر لخته خون در پا ممکن است ایجاد شود، آمبولی ریه است؛ زمانی که بخشی از لخته از محل اولیه جدا شده و به سمت ریه حرکت میکند.
این وضعیت میتواند جریان خون در ریه را مسدود کرده و در عرض چند دقیقه به نارسایی تنفسی، افت شدید اکسیژن خون و مرگ منجر شود. بنابراین، وقتی میپرسیم آیا لخته خون در پا باعث مرگ می شود، باید بدانیم که خطر بالقوه آن کاملاً واقعی است، بهخصوص اگر فرد علائم هشداردهنده مانند درد شدید و ناگهانی در ساق پا، تورم یکطرفه، گرمی پوست ناحیه و یا نفستنگی را نادیده بگیرد. بسیاری از افراد، بهویژه سالمندان یا بیماران بستری، ممکن است متوجه لخته خون نشوند تا زمانی که عوارض جدیتری مانند آمبولی اتفاق بیفتد.
نکته مهم دیگر این است که لخته خون تنها در صورت بیتحرکی طولانی ایجاد نمیشود، بلکه حتی سفرهای هوایی طولانی، استفاده از قرصهای هورمونی یا زمینههای ژنتیکی هم میتوانند زمینهساز باشند. بنابراین اگر در معرض این عوامل خطر قرار دارید، این پرسش که آیا لخته خون در پا باعث مرگ می شود، فقط یک نگرانی فرضی نیست، بلکه یک هشدار پزشکی جدی است.

تغذیه مناسب برای کاهش خطر لخته شدن خون
تغذیه نقش مهمی در پیشگیری از لخته شدن خون ایفا میکند. برخی از مواد غذایی میتوانند به رقیق شدن خون کمک کنند و خطر تشکیل لختهها را کاهش دهند. بهعنوان مثال:
- غذاهای غنی از اسیدهای چرب امگا-3: این اسیدها میتوانند به کاهش التهاب و بهبود سلامت عروق کمک کنند. منابع خوب شامل:
ماهیهای چرب مانند سالمون، تن و ساردین , دانههای چیا و کتان, گردو
- میوهها و سبزیجات: میوهها و سبزیجات حاوی آنتیاکسیدانها و فیبر هستند که به کاهش التهاب و بهبود سلامت قلب کمک میکنند. برخی از آنها عبارتند از:
توتها (توتفرنگی، بلوبری و تمشک),سبزیجات سبز تیره (اسفناج، کلمپیچ و بروکلی),مرکبات (پرتقال، لیمو و گریپفروت)
- غذاهای غنی از ویتامین K: ویتامین K به تنظیم لخته شدن خون کمک میکند. منابع خوب شامل:
سبزیجات برگ سبز مانند کلم، کاهو و کلم بروکلی,روغن زیتون
- غذاهای غنی از فیبر:فیبر به بهبود سلامت دستگاه گوارش و کاهش کلسترول کمک میکند. منابع خوب شامل:
غلات کامل (جو دوسر، برنج قهوهای و نان سبوسدار),حبوبات (عدس، نخود و لوبیا)
- ادویهها و گیاهان: برخی ادویهها و گیاهان خاص میتوانند به بهبود گردش خون کمک کنند:زنجبیل , زردچوبه ,سیر
- آب:نوشیدن آب کافی به هیدراته بودن بدن و جلوگیری از غلیظ شدن خون کمک میکند.
- چای سبز:چای سبز حاوی آنتیاکسیدانهایی است که میتواند به بهبود سلامت قلب و عروق کمک کند.

خوشبختانه، در صورت تشخیص بهموقع، درمانهای موثری مانند داروهای ضدانعقاد خون، جورابهای فشاری و در موارد خاص، جراحی میتوانند از پیشرفت لخته و بروز آمبولی جلوگیری کنند. رعایت موارد پیشگیرانه مانند حرکت دادن پاها هنگام سفر، مصرف مایعات، ترک سیگار و انجام چکاپهای منظم نیز نقش مهمی در کاهش خطر دارد.
در پایان، وقتی از خود میپرسید آیا لخته خون در پا باعث مرگ می شود، بهتر است آن را یک زنگ خطر تلقی کنید تا در صورت مشاهده علائم یا داشتن ریسک بالا، بیدرنگ به پزشک مراجعه کنید و با دریافت درمان مناسب، از بروز عوارض خطرناک پیشگیری نمایید.

چگونه با تغییر سبک زندگی از لخته شدن خون جلوگیری کنیم؟
تغییر سبک زندگی یکی از موثرترین راهها برای پیشگیری از لخته شدن خون است. افزایش فعالیت بدنی، بهویژه ورزشهای هوازی، میتواند به بهبود گردش خون و کاهش احتمال تشکیل لختهها کمک کند. همچنین، توجه به رژیم غذایی و مصرف مواد غذایی غنی از امگا-3، میوهها و سبزیجات تازه، نقش مهمی در پیشگیری دارد.
دیگر تغییرات مؤثر شامل ترک سیگار و کاهش مصرف مشروبات الکلی است. همچنین، کنترل وزن و فشار خون نیز از اهمیت بالایی برخوردار است. در نهایت، مدیریت استرس و خواب کافی میتواند به سلامت کلی بدن کمک کند و از لخته شدن خون جلوگیری کند. با اتخاذ این تغییرات مثبت، میتوان بهطور قابل توجهی خطر لخته شدن خون را کاهش داد.

آیا ورزش کردن بر کاهش احتمال لخته شدن خون تاثیر دارد؟
ورزش کردن بهطور مستقیم بر کاهش احتمال لخته شدن خون تأثیر دارد. فعالیت بدنی منظم باعث بهبود گردش خون و تقویت قلب و عروق میشود. وقتی که بدن در حال حرکت است، جریان خون در رگها افزایش مییابد و این باعث میشود که خطر تجمع پلاکتها و تشکیل لختهها کاهش یابد. ورزشهای هوازی مانند دویدن، شنا و دوچرخهسواری بهویژه برای این منظور موثر هستند.
همچنین، انجام حرکات کششی و تقویتی میتواند به جلوگیری از لخته شدن خون کمک کند. برای افرادی که به مدت طولانی نشستهاند، انجام حرکات کوتاه و راه رفتن در فواصل زمانی مشخص نیز میتواند موثر باشد. در نهایت، ترکیب ورزش با سبک زندگی سالم میتواند بهطور قابل توجهی خطر لخته شدن خون را کاهش دهد.

اثر دیابت و فشار خون بالا در لخته شدن خون
دیابت و فشار خون بالا از عوامل خطر مهم در ایجاد لخته شدن خون به شمار میروند. این بیماریها میتوانند باعث آسیب به عروق خونی شوند و در نتیجه، احتمال تجمع پلاکتها و تشکیل لختهها را افزایش دهند. افراد مبتلا به دیابت ممکن است در معرض خطر بیشتری برای بیماریهای قلبی و عروقی باشند که این وضعیت میتواند به لخته شدن خون منجر شود.
همچنین، فشار خون بالا باعث افزایش فشار در عروق خونی میشود که خود میتواند به ایجاد لختهها کمک کند. برای کاهش این خطرات، کنترل دقیق این شرایط با استفاده از داروها و تغییرات در رژیم غذایی و سبک زندگی بسیار اهمیت دارد. انجام ورزش منظم، مصرف غذاهای سالم و مشاوره با پزشک میتواند به مدیریت این بیماریها و در نتیجه، کاهش خطر لخته شدن خون کمک کند.
خطرات لخته خون در افراد مسن و روشهای مراقبتی
لخته خون یکی از خطرات جدی برای افراد مسن است. با افزایش سن، خطر ابتلا به بیماریهایی که میتوانند منجر به لخته شدن خون شوند، افزایش مییابد. همچنین، حرکت کم و بیماریهای مزمن مانند دیابت و فشار خون بالا، این خطر را تشدید میکند. برای کاهش این خطر، توجه به سبک زندگی و عادات روزمره ضروری است.
نکاتی برای کاهش خطر لخته شدن خون در پا پس از عمل جراحی
پس از عمل جراحی، خطر لخته شدن خون افزایش مییابد. به همین دلیل، رعایت نکات پیشگیرانه بسیار حائز اهمیت است. یکی از اصلیترین راهها برای کاهش این خطر، فعالیت بدنی مناسب است. پزشکان معمولاً به بیماران توصیه میکنند که بهمحض امکان، حرکات ملایم را آغاز کنند تا جریان خون بهبود یابد. همچنین، استفاده از جورابهای فشاری میتواند به کاهش ورم و جلوگیری از لخته شدن خون کمک کند.
در طول دوره بهبودی، مصرف مایعات کافی و پرهیز از نشستن طولانیمدت نیز ضروری است. پزشک ممکن است داروهای رقیقکننده خون را نیز تجویز کند تا از تشکیل لختهها جلوگیری شود. در نهایت، توجه به علائم لخته شدن خون و مشاوره با پزشک در صورت بروز هرگونه مشکل، بسیار مهم است.

نقش دستگاههای IPC در پیشگیری از لخته خون
دستگاههای IPC (Intermittent Pneumatic Compression) یکی از فناوریهای نوین در پیشگیری از لخته شدن خون هستند. این دستگاهها بهطور متناوب بر روی پاها فشار وارد میکنند و به بهبود گردش خون کمک میکنند. این روش بهویژه در بیمارانی که در معرض خطر بالای لخته شدن خون هستند، مانند بیماران جراحی یا افرادی که برای مدت طولانی بیحرکت هستند، مؤثر است.
استفاده از دستگاههای IPC میتواند به کاهش خطر ترومبوز ورید عمقی و آمبولی ریه کمک کند. همچنین، این روش بدون عوارض جانبی جدی است و به راحتی در بیمارستانها و مراکز درمانی قابل استفاده است. در نتیجه، دستگاههای IPC بهعنوان یک ابزار مهم در برنامههای پیشگیری از لخته خون شناخته میشوند.
بیشتر بخوانید: راهنمای استفاده از دستگاه IPC
لخته شدن خون طبیعی و غیرطبیعی چیست؟
لخته شدن خون یک فرآیند طبیعی است که به جلوگیری از خونریزی در بدن کمک میکند. زمانی که عروقی آسیب میبیند، لختهای تشکیل میشود تا جلوی خروج خون را بگیرد. این نوع لخته شدن خون برای سلامت بدن ضروری است. اما گاهی اوقات، لختهها در جاهای نادرست و غیرطبیعی تشکیل میشوند که میتوانند منجر به مشکلات جدی شوند. بهعنوان مثال، لخته شدن خون در وریدهای عمقی پاها میتواند به ترومبوز ورید عمقی (DVT) و در نتیجه آمبولی ریه منجر شود.
عوامل مختلفی میتوانند باعث لخته شدن خون غیرطبیعی شوند، از جمله چاقی، بیماریهای قلبی، و عدم تحرک. علائم این نوع لختهها میتواند شامل ورم، درد و تغییر رنگ در ناحیه آسیبدیده باشد. درمان لخته خون غیرطبیعی معمولاً شامل استفاده از داروهای رقیقکننده خون و در برخی موارد، جراحی برای حذف لختهها است. پیشگیری از لخته شدن خون غیرطبیعی با تغییرات در سبک زندگی مانند ورزش منظم، مصرف غذای سالم و پرهیز از سیگار کشیدن امکانپذیر است. در نهایت، تشخیص و درمان زودهنگام این وضعیت میتواند از عوارض جدی جلوگیری کند.
بیشتر بخوانید: از خطرات آمبولی در بارداری باخبر شوید!

نکاتی برای کاهش خطر لخته شدن خون در زندگی روزمره
کاهش خطر لخته شدن خون در زندگی روزمره نیاز به توجه و مراقبت دارد. یکی از مهمترین نکات، افزایش فعالیت بدنی است. ورزش منظم، حتی به مدت 30 دقیقه در روز، میتواند به بهبود گردش خون و کاهش احتمال تشکیل لختهها کمک کند. همچنین، نوشیدن مایعات کافی و مصرف غذاهای سالم و مغذی از جمله میوهها و سبزیجات تازه، نقش مهمی در پیشگیری از لخته شدن خون دارد.
پرهیز از سیگار کشیدن و کاهش مصرف مشروبات الکلی نیز از اهمیت بالایی برخوردار است. در روزهای طولانی، بهویژه هنگام نشستن برای مدت طولانی، بهتر است هر از گاهی بلند شوید و چند قدمی راه بروید.
همچنین، استفاده از جورابهای فشاری میتواند به کاهش ورم و بهبود گردش خون کمک کند. توجه به علائم لخته شدن خون و مراجعه به پزشک در صورت بروز هرگونه مشکل نیز اهمیت دارد. با رعایت این نکات ساده، میتوان خطر لخته شدن خون را بهطور قابل توجهی کاهش داد و سلامت خود را بهبود بخشید.









